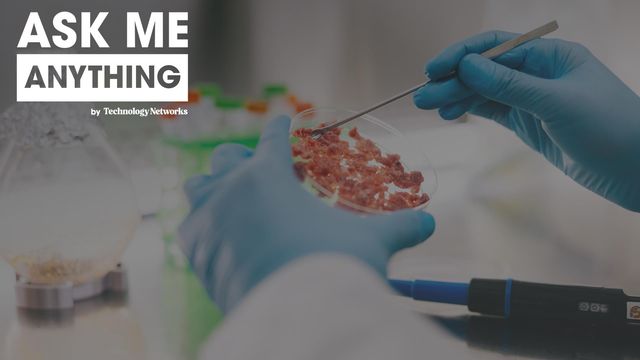
Scientist in blue gloves examines cultured meat in a petri dish using a metal tool, with lab equipment in the background.

Ask Me Anything
Ask Me Anything: Next-Generation Battery Technologies
On-Demand
Join Dr. Boryann Liaw for a live Ask Me Anything on battery innovation. Explore solid-state modeling, fast charging, diagnostics and simulation. Gain expert insights into the future of electrification, renewables and sustainable energy storage.

Ask Me Anything
Ask Me Anything: PFAS Contamination
On-Demand
On April 28, join us for a live session with Prof. Rainer Lohmann to ask your questions about per- and polyfluoroalkyl substances. This is your chance to engage with a leading expert in environmental and analytical chemistry.
Ask Me Anything
Ask Me Anything: Future Foods
On-Demand
Join us for an exclusive Ask Me Anything session where you’ll learn about the latest advances and challenges in cell culture media, cellular agriculture and cultivated meat.

Ask Me Anything
Ask Me Anything: PFAS
On-Demand
Join us on October 29 for an hour-long virtual session where you’ll have the unique opportunity to ask your PFAS questions directly to our expert speaker, Dr. Ian Ross, in real time.

Ask Me Anything
Ask Me Anything: Battery Research
On-Demand
The future of sustainable energy hinges on next-generation battery technology. We're excited to announce an exclusive live Ask Me Anything session focused entirely on battery research!

Ask Me Anything
Ask Me Anything: Nanotechnology
On-Demand
This exclusive AMA offers a rare opportunity to engage directly with Dr. Thomas Webster, a world-renowned biomedical engineer and entrepreneur with over 28 years of experience at the forefront of nanotechnology. Dr. Webster is well known for his pioneering work in harnessing the power of nanomaterials to revolutionize healthcare applications.
Advertisement

